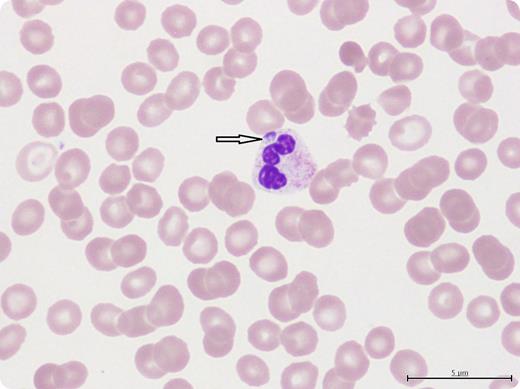
A 63-year-old woman presented with fever, confusion, dysarthria (slurred speech), new-onset thrombocytopenia (26 × 109/L platelets) and mild transaminitis 2 weeks after a tick bite to the left thigh. Physical examination was negative for splenomegaly, rash, or any other focal deficits. A review of the peripheral smear confirmed morulae inside the neutrophils suggestive of a diagnosis of human granulocytic anaplasmosis (HGA). Serologies for Lyme disease, Rocky Mountain spotted fever, ehrliciosis, and anaplasmosis were negative. A reverse-transcription polymerase chain reaction for HGA was positive. Anaplasma antibodies may take 2 to 3 weeks to become positive and thus have low negative predictive value in acute presentations. The patient responded well to intravenous doxycycline with recovery of platelets (>200 × 109/L), resolution of fever, transaminitis, and confusion. At the time of discharge, she still had dysarthria as an unusual isolated neurological manifestation of HGA not reported before. Computed tomography scan and magnetic resonance imaging of the brain did not show any lesions that could explain dysarthria. / Review of peripheral smear in patients with thrombocytopenia and history of tick bite should focus on inclusion bodies in granulocytes and monocytes.

A 63-year-old woman presented with fever, confusion, dysarthria (slurred speech), new-onset thrombocytopenia (26 × 109/L platelets) and mild transaminitis 2 weeks after a tick bite to the left thigh. Physical examination was negative for splenomegaly, rash, or any other focal deficits. A review of the peripheral smear confirmed morulae inside the neutrophils suggestive of a diagnosis of human granulocytic anaplasmosis (HGA). Serologies for Lyme disease, Rocky Mountain spotted fever, ehrliciosis, and anaplasmosis were negative. A reverse-transcription polymerase chain reaction for HGA was positive. Anaplasma antibodies may take 2 to 3 weeks to become positive and thus have low negative predictive value in acute presentations. The patient responded well to intravenous doxycycline with recovery of platelets (>200 × 109/L), resolution of fever, transaminitis, and confusion. At the time of discharge, she still had dysarthria as an unusual isolated neurological manifestation of HGA not reported before. Computed tomography scan and magnetic resonance imaging of the brain did not show any lesions that could explain dysarthria.
Review of peripheral smear in patients with thrombocytopenia and history of tick bite should focus on inclusion bodies in granulocytes and monocytes.
A 63-year-old woman presented with fever, confusion, dysarthria (slurred speech), new-onset thrombocytopenia (26 × 109/L platelets) and mild transaminitis 2 weeks after a tick bite to the left thigh. Physical examination was negative for splenomegaly, rash, or any other focal deficits. A review of the peripheral smear confirmed morulae inside the neutrophils suggestive of a diagnosis of human granulocytic anaplasmosis (HGA). Serologies for Lyme disease, Rocky Mountain spotted fever, ehrliciosis, and anaplasmosis were negative. A reverse-transcription polymerase chain reaction for HGA was positive. Anaplasma antibodies may take 2 to 3 weeks to become positive and thus have low negative predictive value in acute presentations. The patient responded well to intravenous doxycycline with recovery of platelets (>200 × 109/L), resolution of fever, transaminitis, and confusion. At the time of discharge, she still had dysarthria as an unusual isolated neurological manifestation of HGA not reported before. Computed tomography scan and magnetic resonance imaging of the brain did not show any lesions that could explain dysarthria.
Review of peripheral smear in patients with thrombocytopenia and history of tick bite should focus on inclusion bodies in granulocytes and monocytes.
For additional images, visit the ASH IMAGE BANK, a reference and teaching tool that is continually updated with new atlas and case study images. For more information visit http://imagebank.hematology.org.